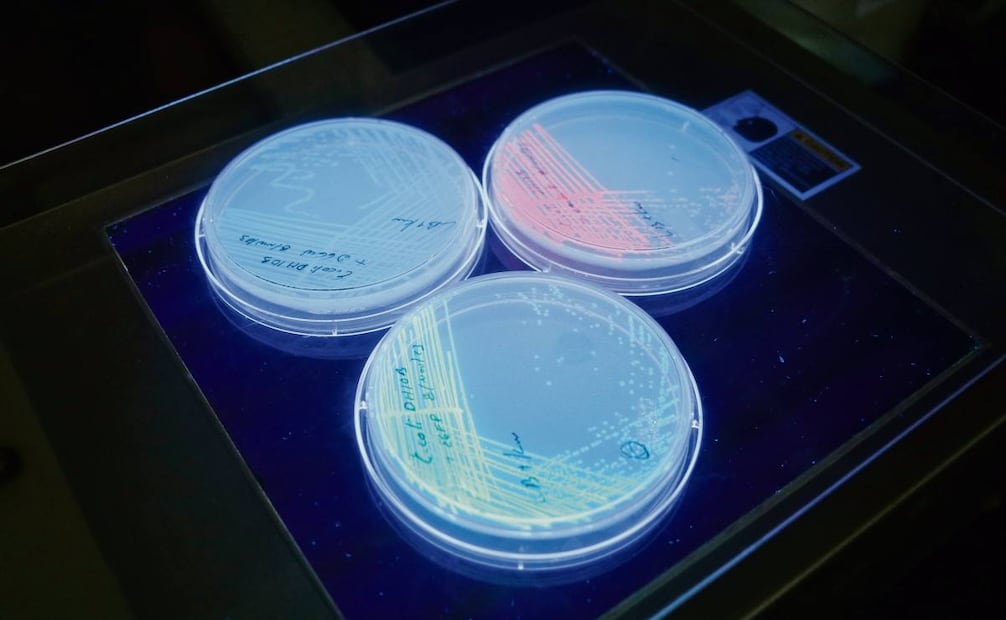
Biobanco. La institución desarrolla el Mapa genético de los mexicanos que ayudará a diseñar tratamientos. Foto: Efrén Díaz / Cinvestav

[Publicidad]
El Centro de Investigación y de Estudios Avanzados (Cinvestav) celebra mañana sus 65 años de vida, consolidado como el centro de investigación número 1 en México según el Ranking del Consejo Superior de Investigaciones Científicas de España de 2024 y con más de 18 mil estudiantes de posgrado graduados, y también con infinidad de proyectos de investigación, de entre los cuales tres son de gran calado: la coordinación, junto con el INAOE, del Centro de Diseño de Semiconductores Proyecto Kutsari, impulsado por el gobierno de México; la conclusión del Biobanco Mexicano (MX Biobank), que es el mapa genómico de los mexicanos; un proyecto de banco de germoplasmas e investigación de enfermedades degenerativas en la población en etapa de vejez, en el Centro de Investigación sobre el Envejecimiento.
El 17 de abril de 1961, en Zacatenco, se inauguró este centro adscrito al IPN, que mañana tendrá una ceremonia con autoridades educativas y científicas. En 65 años ha graduado a 6 mil investigadores de doctorado y 12 mil de maestría que están activos en 29 países. 27 son Premios Nacional de Ciencias y 8 miembros de El Colegio Nacional.
Desde su creación se ha dedicado a dos tareas sustanciales: la formación de investigadores y desarrollar investigación científica y tecnológica para beneficio del país. Así, a lo largo de 65 años ha creado 12 unidades en Guadalajara, Irapuato, Mérida, Saltillo, Monterrey, Querétaro, Tamaulipas, Tlaxcala, Zacatenco, Sede Sur, Ábacus y Genómica Avanzada. De donde salen cada año 600 investigadores, 12% son extranjeros.
Lee también Samuel García inaugura Foro de Semiconductores México–EU; impulsa colaboración tecnológica

El Centro ha sido parte de proyectos medulares del Estado; sus investigadores también están en proyectos internacionales de física de partículas y altas energías como el CERN, Fermilab, DESY y KEK. El doctor Alberto Sánchez, director general del Cinvestav, así como el doctor Abdel Pérez Lorenzana, secretario Académico, y la doctora Janet Murbatián, secretaría de Planeación, en entrevista con EL UNIVERSAL hablan de los logros, así como de su colaboración en proyectos nacionales prioritarios, como el Centro de Diseño de Semiconductores Kutsari y el Centro Mexicano de Supercómputo. Además de proyectos en desarrollo en sus 10 laboratorios de genómica, bioseguridad, biomateriales y envejecimiento, entre otros. También de los retos en ejercicio presupuestario, becas, relevo generacional y paridad de género.
“Cinvestav es una pieza esencial en el desarrollo de la ciencia en México. Llega con esta experiencia acumulada y con la posibilidad de seguir impactando en el desarrollo tecnológico que se está impulsando en esta administración”, asegura el doctor Sánchez, quien agrega a lo lardo de estos 65 años el centro se ha posicionado no solo a nivel nacional, sino internacional, “la calidad de nuestros graduados es reconocida, tan solo en México tenemos más de 30 tesis de doctorado con el premio Weizmann, a la mejor tesis doctoral en el país”.
Uno de los grandes proyectos actuales en materia de tecnología y ciencia es sobre semiconductores, que coordinan desde la unidad Guadalajara, que “está enfocada al diseño de chips con la intención de empujar y sentar las bases de para que en corto plazo podamos generar nuestra propia tecnología electrónica”, afirma Pérez Lorenzana.
Lee también Perú y Brasil firman acuerdo científico; impulsan innovación y protección de la Amazonía
El doctor Sánchez apunta: “Estamos en la primera fase. En el proceso de diseño de, por ejemplo, un teléfono, cerca del 60% es el diseño, la idea. Y es ahí donde estamos, en la parte más rentable y que requiere de menos inversión”.
Apunta que el desafío es tener la posibilidad de ir reemplazando todas las importaciones que hoy hacemos, por producción propia. “Es un proyecto con mucha visión a futuro y esperamos que impacte al desarrollo tecnológico del país”. Hasta ahora “se están trabajando en algunos diseños de seguridad nacional que no podemos revelar. La idea es ir haciendo diseño de chips multiusos que se puedan reemplazar: controlar tarjetas de acceso, bien podríamos diseñar el chip de nuestros pasaportes o nuestras identificaciones, empezar con algo sencillo, pero que ya sea mexicano”.
Destaca también los desarrollos en edición genética, como es el Biobanco. “Si nosotros conocemos a mayor detalle el genoma de la población mexicana, podemos diseñar tratamientos, medicinas, lo que se requiera para atacar las enfermedades que tenemos. Sería medicina de precisión, más eficiente y precisa”.

Pérez Lorenzana apunta que una apuesta en los últimos años ha sido consolidar más becas y proyectos; e incorporar a más mujeres investigadoras, jefas de departamento y directoras de unidad, e incentivar el relevo generacional, “hemos contratado a jóvenes investigadores en los últimos cuatro años, en promedio entre 10 y 15 por año, lo que nos ha permitido ir haciendo esta renovación”
El Cinvestav, a sus 65 años, cuenta con infraestructura e investigación de primer nivel, como asegura la doctora Murbatián, “la idea es tener un laboratorio con infraestructura moderna y actualizada”, y agrega: “Nuestros números siguen demostrando que ésta es una institución sólida y que sigue adelante, pero requiere también el apoyo del Gobierno Federal para que esto siga manteniéndose al nivel que estamos acostumbrados”.

Únete a nuestro canal ¡EL UNIVERSAL ya está en Whatsapp!, desde tu dispositivo móvil entérate de las noticias más relevantes del día, artículos de opinión, entretenimiento, tendencias y más.
[Publicidad]

